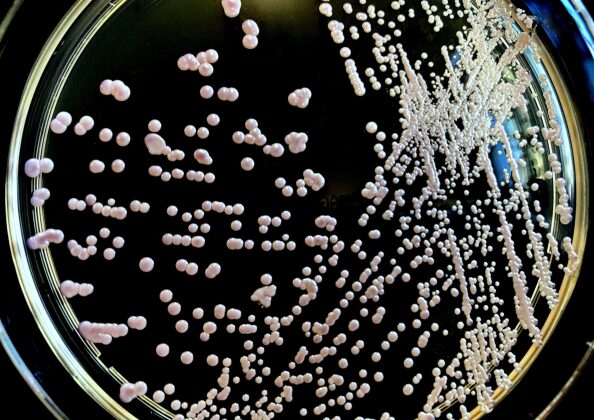
「発酵に関与する酵母菌の培養画像｜微生物の働きと食品発酵の科学的メカニズムを示す実験例」

醸造と発酵:健康効果を科学的に解説|腸内環境・栄養吸収の秘密
毎日の食卓に欠かせない味噌や醤油、ヨーグルト、チーズ。これらの発酵食品がどのようにして生まれるのか、考えたことはありますか?実は、微生物の驚くべき働きと人間の知恵が組み合わさることで、シンプルな材料から豊かな風味と栄養価を備えた食品が誕生しています。
本記事では、発酵と醸造の基本メカニズムから、健康志向の人が知りたい栄養効果、そして環境への貢献まで、わかりやすく解説します。日本の伝統的な発酵食品を通じて、食の本質に迫ってみましょう。

発酵と醸造:微生物が織りなす食の奇跡
毎日の食卓に登場する味噌や醤油、ヨーグルトなど。これらは一体どのようにして作られ、私たちの健康にどのような影響を与えているのでしょうか?その答えは、目に見えない微生物たちの驚くべき働きにあります。この章では、発酵と醸造の違いから、微生物がどのようにして食品を変化させるのか、その仕組みを解き明かしていきます。
発酵と醸造は何が違う?
発酵」と「醸造」という言葉は混同されやすいですが、異なるプロセスです。
発酵は、酵母や乳酸菌、カビなどの微生物が糖やデンプンを分解する自然なプロセスです。酵母はアルコールと二酸化炭素を、乳酸菌は乳酸を生成することで、食品に風味や酸味をもたらし、保存性を高めます。ヨーグルト、納豆、漬物といった身近な食品は、微生物の活動によって生まれています。
醸造は、この発酵をさらに深掘りしたもので、人間が意図的に条件(温度、湿度、時間)を整えて微生物の活動をコントロールする技術です。日本酒、ビール、味噌、醤油といった複雑な風味を持つ食品は、すべて醸造によって生み出されます。職人の知識と科学的な管理が融合した結果、多様で豊かな味わいが実現するのです。

微生物の働き:小さな生命が変える食卓
発酵のカギを握るのは、目に見えない微生物たちです。主要な微生物の役割を見てみましょう。
酵母は、糖をアルコールと二酸化炭素に分解します。この反応により、ワインやビール、日本酒が生まれ、パンの生地も膨らみます。酵母は20~30℃の温暖な環境で活発に活動し、温度管理がビールの軽やかさと濃厚さの違いを生み出します。
乳酸菌は、糖を乳酸に変え、ヨーグルトや漬物の特有の酸味を創出します。同時にpH(酸性度)を下げることで、腐敗菌の増殖を抑え、食品の保存性を格段に高めます。腸内フローラを整えるプロバイオティクスとしても注目されており、健康志向の人にとって重要な存在です。
**麹菌(こうじきん)**は、日本の発酵文化を支える主役です。デンプンを糖に分解する酵素を分泌し、味噌や日本酒の醸造を可能にします。この複雑な分解プロセスが、独特の香りと旨味を生み出すのです。

健康志向なら知っておきたい:発酵食品の健康効果
現代人が抱える「腸内環境の乱れ」「栄養不足」「免疫力の低下」といった悩みは、実は発酵食品で解決できることをご存知ですか?この章では、発酵食品が私たちの身体にもたらす具体的な健康効果を、科学的根拠に基づいて解説します。毎日の食卓に発酵食品を取り入れることが、いかに重要であるかを理解できるでしょう。
腸内環境を整える発酵食品
現代人の多くが抱える悩みのひとつが「腸内環境」です。発酵食品は、この課題に自然なアプローチを提供します。
ヨーグルトや納豆に含まれる乳酸菌やビフィズス菌は、腸内の善玉菌を増やし、腸内フローラのバランスを改善します。最近の研究では、定期的にヨーグルトを摂取する人は風邪をひきにくいことが報告されており、腸内環境が免疫力と深く関わっていることが示唆されています。
味噌やぬか漬けなどの伝統的な発酵食品も、天然の乳酸菌を豊富に含んでいます。毎日の食卓に1杯の味噌汁を加えるだけで、腸内環境を整えるサポートができるのです。
栄養吸収を高める発酵のチカラ
発酵は単に新しい風味を生み出すだけでなく、栄養価そのものを向上させます。
豆を発酵させた味噌や納豆では、タンパク質がアミノ酸に分解され、身体が吸収しやすい形に変わります。同時に、ビタミンB群やビタミンK2といった栄養素が増加。特にビタミンK2は骨の健康を保つのに欠かせない成分で、味噌を食べることで骨密度の維持をサポートできます。
また、乳糖不耐症の方でも安心して楽しめるのが発酵食品の魅力です。ヨーグルトの製造過程で乳糖が分解されるため、牛乳では避けていた人でも栄養を取り入れられます。
抗酸化作用で健康寿命をサポート
味噌に含まれるペプチドやイソフラボンには、強い抗酸化作用があります。これらの成分は、体内の活性酸素を抑制し、老化や生活習慣病の予防に役立ちます。
長野県は味噌の消費量が全国で最も多く、同時に健康寿命が長いことで知られています。このデータは、日常的な発酵食品の摂取と健康寿命の関係を暗示しているのです。
日本の伝統と世界の醸造文化
発酵食品は日本だけでなく、世界中で古くから愛されてきた食べ物です。味噌や醤油といった日本の伝統的な調味料から、ビールやワインといった西洋の醸造文化まで、各地域の風土と人々の知恵が生み出した、独特の食文化が存在します。このセクションでは、日本と世界の醸造文化の歴史と、それぞれが持つ特徴を探ってみましょう。
日本が誇る味噌と醤油
味噌と醤油は、日本の食文化を象徴する調味料です。その歴史は古く、7世紀に中国から伝わった「醤(ひしお)」に遡ります。平安時代には貴族の珍重品となり、江戸時代には庶民の食卓にも広がりました。
特に注目すべきは、地域ごとに異なる個性です。赤味噌、白味噌、麦味噌など、米麹や麦麹の配合、大豆の品種によって、全く異なる風味が生まれます。木桶での自然発酵によって得られる深い香りは、化学調味料では決して再現できません。職人たちが数年かけて熟成させることで生まれるまろやかな風味は、日本の食を支える基盤となっているのです。

ビールとワイン:世界が愛する醸造文化
ビールの起源は紀元前4000年頃のメソポタミアにまで遡ります。中世ヨーロッパでは修道院がビール造りを洗練させ、1516年のドイツの「ビール純粋令」により、麦芽、ホップ、水、酵母のみを使用するという基準が確立されました。この厳格な基準こそが、ビール文化の信頼性を生み出したのです。
ワインもまた、紀元前6000年頃からコーカサス地方で愛されてきた飲み物です。ブドウの自然発酵と樽での熟成によって、複雑で多層的な香りが生まれます。赤ワインの渋みや白ワインの爽やかさは、時間と微生物の働きがもたらす奇跡なのです。

食卓を豊かにする発酵と醸造
時間と技術、微生物の働きが織りなす発酵食品は、単に栄養価の高さだけではなく、私たちの食卓と人生にもたらす豊かさがあります。毎日の一杯の味噌汁、一滴の醤油がどのように身体と心に働きかけるのか、そして地球の未来にどのように貢献するのかを、このセクションで探ってみましょう。
一滴の醤油、一杯の味噌汁が変える食事の質
毎日の食卓に登場する味噌や醤油は、単なる調味料ではありません。大豆と麹が時間をかけて熟成する過程で、アミノ酸や有機酸が生成され、数百種類の香気成分が醤油に深い奥行きを加えます。
刺身にサッと垂らした醤油、スープの隠し味として加えた味噌。こうした小さなひと手間が、食事を特別なものに変えます。健康志向の人にとって、発酵食品の活用は「ただおいしい」ではなく、「身体に優しい栄養を効率よく摂る」という目的を同時に実現する選択なのです。
環境への配慮:持続可能な食の未来
発酵は、資源を効率よく活用する技術として、環境問題の解決にも貢献しています。
世界では毎年13億トン以上の食料が廃棄されていますが、発酵はその削減策として期待されています。野菜の切れ端や果物の皮を発酵させれば、新たな食材に生まれ変わります。実際に、オランダでは廃棄予定のパンをビールに変えるプロジェクトが成功し、地元で人気を博しています。
また、食品残渣をメタン発酵させてバイオガスを生成する技術は、化石燃料の代替として注目されています。こうした応用は、少ないエネルギーで高い価値を生み出す、サステナブルな食の形を実現しているのです。
時間と技が紡ぐ、未来への物語
醸造と発酵は、過去から現在、そして未来へと続く、人類の食を支える物語です。微生物と人間の知恵が共鳴し、時間と技術によって紡がれた食の奇跡は、単に栄養価の高さや風味の豊かさだけではなく、環境への配慮や健康寿命の延伸といった、私たちが本当に求めている価値を実現しています。
毎日の1杯の味噌汁、1滴の醤油の中に、数千年の歴史と現代の科学、そして未来への可能性が詰まっています。健康志向のあなたが選ぶ発酵食品は、単なる食べ物ではなく、自分の健康と地球の未来に投資する選択なのです。
琉樹商店では、伝統の手作り味噌を通じて、こうした発酵の魅力をお届けしています。にんにくや唐辛子を使った商品も、忙しい日々の中で、手軽に発酵食品の恩恵を受けていただくために開発されました。時を超える醸造と発酵の物語を、ぜひ、あなたの食卓で体験してください。
千葉県産「房の恵味」シリーズ 販売中!
この度、琉樹商店では千葉の海と大地の恵みを味噌に込めて 千葉県の魅力的な食材と味噌を組み合わせた「房の恵味」シリーズをお届けします。



炊き立てのご飯にのせれば、それだけでごちそうに。酒の肴や、炒め物、煮ものの味付けにも活躍します。
関連記事







![宮城県産「ひとめぼれ」※送料込み 5kg[限定10個セール] クーポンコードにryukishotenと入れていただくと、送料が無料になります。](https://ryukishouten.com/ryukishouten/wp-content/uploads/2025/09/e62c1c38ebeaf79c94d41abb0f5f5fd3-225x300.jpg)




